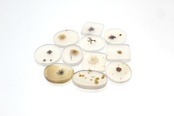
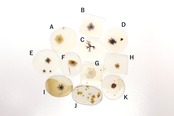
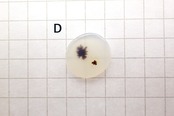
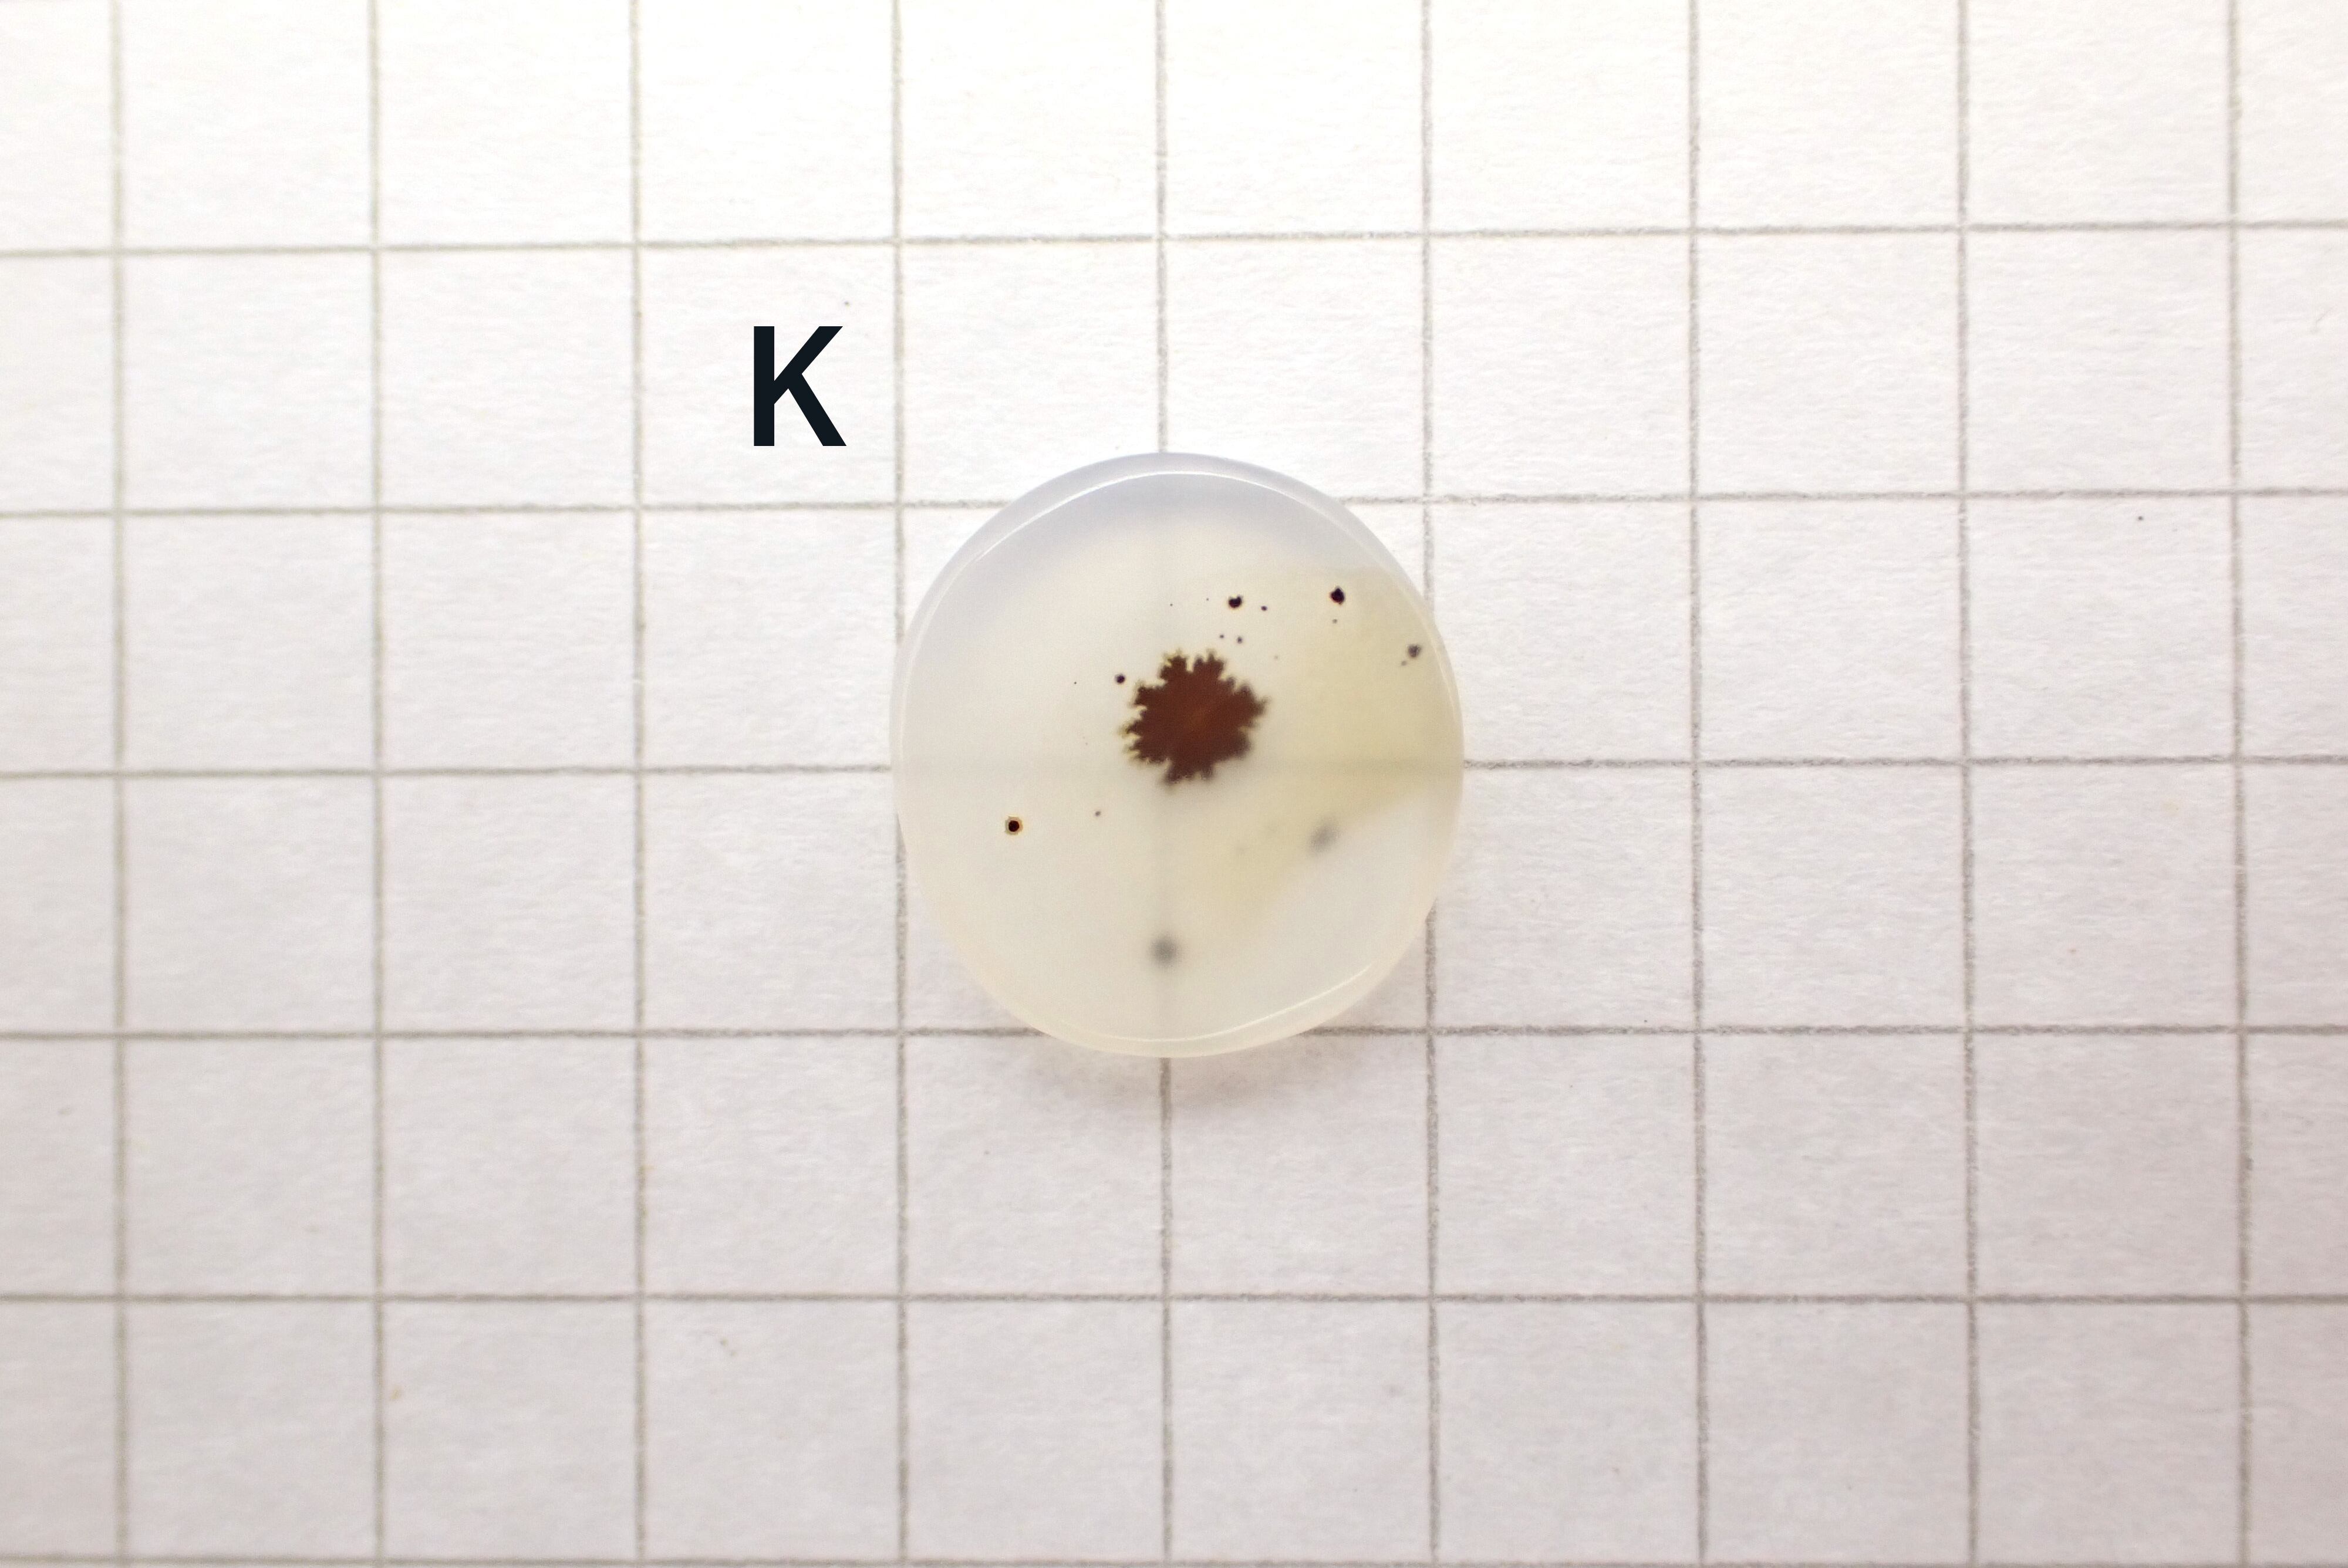

1/14
731 dendritic agate*
¥1,400 税込
なら 手数料無料で 月々¥460から
石の中に樹枝が入っているように見える不思議なアゲート。
ギリシャ語の『dendron(デンドロン)』から由来して、樹枝状の結晶を『dendraite(デンドライト)』と呼び、その結晶の入ったアゲートやクォーツを『デンドリティックアゲート』『デンドリティッククォーツ』と呼びます。
デンドライトは本物の植物ではなく、水晶などの欠けた部分に酸化マンガンや酸化鉄などが入り込んだことによって、樹枝のような模様が現われたものです。
アートのようにも楽しめるデンドリティックはとても人気の石で、透明感のあるクォーツに比べてやや白く曇っているアゲートはさらにノスタルジックな雰囲気も感じさせます。
はっきりしたシダ植物のようなモノから墨を垂らしたような濃いモノなど、一つとして同じ模様はない為、ついたくさん集めて眺めたくなってしまうような魅力のある石です。
心に残る石に出会えましたらぜひお迎えください。
※サイズの目安は4枚目以降の画像をご参考ください。(マス目は5×5mmです。)
『dendritic agate*』←末尾に『*』のついているデンドリティックアゲートは低価格用ルースです。
大きさに対してかなりお安く提供しております。
まれに小さなクラックや石留に支障のないレベルの面ダレが含まれる場合がございますので画像をよくご確認ください。
-
レビュー
(162)
-
送料・配送方法について
-
お支払い方法について
¥1,400 税込
最近チェックした商品
同じカテゴリの商品
セール中の商品
その他の商品